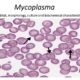

In 2024, Omidyar Network and WeWork Inc. announced their exit from the Indian market due to adverse business conditions, while...












This article we will discuss about Secondary Growth in Dicot Stem & Root Notes By the activity of lateral meristems, formation of secondary tissue which leads...

In this article we will discuss about the Pongamia pinnata :- common name, scientific name, medicinal uses and photos. Common name English: Indian beech tree, Hongay...

After reading this article you will learn about Aves General Characteristics, Classification and Examples Aves General Characteristics All types of birds are included in this class...

Cell The Unit of Life Class 11 Notes What is a cell? Cell is the building block of all living organisms Discovery of cells In 1665,...
In this article we will discuss about characteristics of mycoplasma Characteristics of Mycoplasma Mycoplasma are the smallest known living organisms and it lack cell wall. They...

Download Biotechnology and its Applications NEET Notes PDF, Biotechnology and its Applications Biology Class 12 Notes, Biotechnology and its Applications PDF Download:- Hello dear students, get Free...

In this article we will discuss about the frog nervous system Frog Nervous System The set of organs which control and coordinate all the activities of...

In this article we will discuss about the cockroach morphology Cockroach Morphology Cockroaches are brown or black bodied animals Inhabiting the unhygienic and damp places Cockroaches...

Download Organisms and Populations NEET Notes PDF, Organisms and Populations Biology Class 12 Notes, Organisms and Populations PDF Download:- Hello dear students, get Free Organisms and Populations...

In this article we will discuss about difference between chromoplast and chloroplast Difference Between Chromoplast and Chloroplast 1. Pigment Content: Chloroplasts contain chlorophyll pigments, which give them...